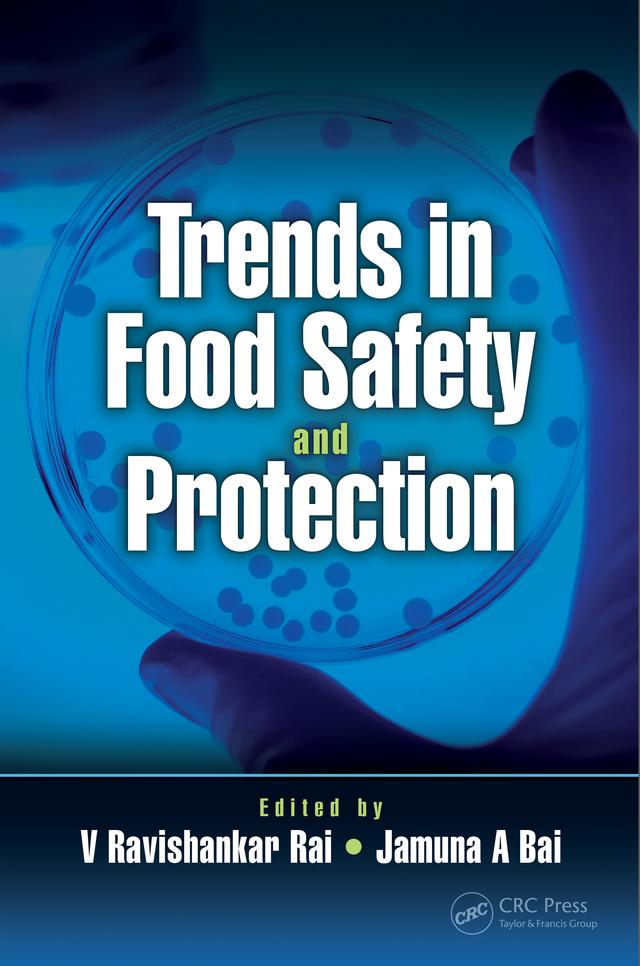
Trends in Food Safety and Protection by Jamuna A Bai, V Ravishankar Rai

Kurslitteratur inom Kostvetenskap & näringslära
All kurslitteratur du behöver för studier inom Kostvetenskap & näringslära. Här hittar du ett brett utbud av e-böcker inom Kostvetenskap & näringslära hos oss. Hittar du inte vad du söker? Sök på ISBN, titel eller författare.
1 257 Böcker